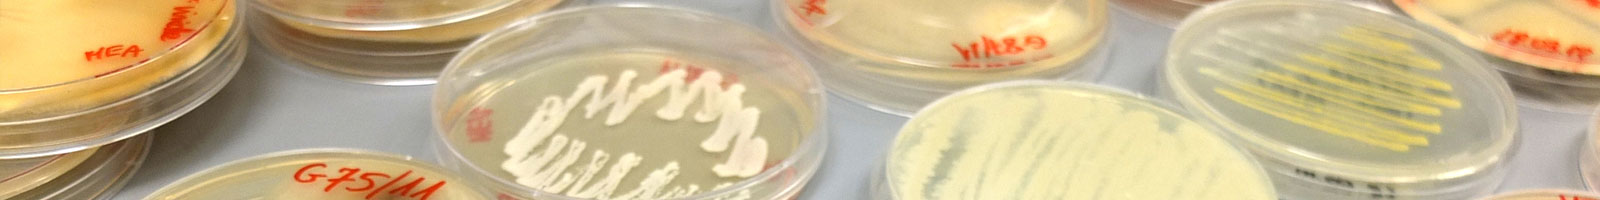

Kierownik: prof. dr hab. Magdalena Frąc, czł. koresp. PAN
Strategicznym celem badań jest szeroko-pojęta charakterystyka jakości środowiska rolniczego oraz opracowanie i testowanie rozwiązań biotechnologicznych dla zrównoważonego, ekologicznego i regeneracyjnego rolnictwa, które uwzględniają zagospodarowanie produktów odpadowych z przemysłu rolno-spożywczego, właściwości gleby, bioróżnorodność mikroorganizmów oraz poznanie i zrozumienie ich funkcji w agroekosystemach, a także wyjaśnienie mechanizmów odpowiedzi roślin i mikrobioty na biotyczne i abiotyczne stresy środowiskowe.

Koncepcja holobiontu roślinnego. Rośliny postrzegane są jako metaorganizmy współistniejące z mikroorganizmami, z którymi komunikują się poprzez wymianę molekuł sygnalnych, metabolitów oraz składników odżywczych. Badania obejmują rozpoznanie składu i funkcji mikrobiomu roślin zdrowych i symptomatycznych wraz z określeniem transferu mikrobioty bakteryjnej i grzybowej w obrębie nisz ekologicznych holobiontu roślinnego.
Mikrobiom glebowy. Badania obejmujące rozpoznanie mikrobiomu gleb oraz określenie zmian mikrobiomu glebowego pod wpływem różnych czynników środowiskowych i antropogenicznych, systemów uprawy, nawożenia, biostymulatorów, sposobu użytkowania gruntu oraz uprawianej rośliny.
Interakcje gleba-roślina-mikrobiom. Badania ukierunkowane na aspekty obejmujące zależności w systemie gleba-roślina-mikrobiom, zmierzające do rozpoznania zbiorowisk mikroorganizmów środowiska rolniczego oraz ich roli w procesach i szlakach metabolicznych zachodzących w glebie i roślinie oraz istotnych dla produkcji wysokiej jakości żywności. Określenie interakcji gleba-roślina-mikrobiom dla rozwoju zrównoważonych strategii produkcji roślinnej. Wykorzystanie kompleksowej analizy bioinformatycznej i podejścia metataksonomicznego do monitorowania zdrowia gleb i roślin.
 Stresy abiotyczne a wzrost i plonowanie roślin. Badania nad wpływem oddziaływania czynników środowiskowych na wzrost, funkcjonowanie i plonowanie roślin uprawnych wzrastających w warunkach stresowych.
Stresy abiotyczne a wzrost i plonowanie roślin. Badania nad wpływem oddziaływania czynników środowiskowych na wzrost, funkcjonowanie i plonowanie roślin uprawnych wzrastających w warunkach stresowych.
Mikrolistki (microgreens). Mikrolistki należą do superżywności produkowanej w ramach rozwijającego się rolnictwa miejskiego i wertykalnego. Badania interakcji mikrolistków i mikrobiomów jako funkcjonalnych regulatorów ich jakości, odporności i trwałości.
Opracowanie i testowanie rozwiązań biotechnologicznych dla zrównoważonego i ekologicznego rolnictwa. Opracowanie i testowanie biopreparatów, nawozowych produktów mikrobiologicznych, bionawozów, bioproduktów i biostymulatorów wzrostu roślin oraz istotnych dla utrzymania zdrowych gleb.
Ekologia i biochemia mikroorganizmów. Analiza właściwości biochemicznych oraz wrażliwości chemicznej mikroorganizmów środowiskowych, w tym grzybów termoopornych oraz mikroorganizmów dobroczynnych, w celu pozyskania szczepów o potencjalnym znaczeniu biotechnologicznym oraz wyjaśnienia mechanizmów odpowiedzialnych za regulację ich szlaków metabolicznych.
Multiomiczne ujęcie wirulencji inwazyjnych fitopatogenów i ich wpływ na holobiont. Badania ukierunkowane na kompleksową analizę genomiki, transkryptomiki i profilu metabolicznego w celu identyfikacji mechanizmów wirulencji, adaptacji oraz rozprzestrzeniania się mikroorganizmów patogenicznych atakujących rośliny uprawne.
Analiza mikrobiologiczna surowców roślinnych. Opracowywanie, optymalizacja i testowanie metod szybkiej detekcji i eliminacji mikroorganizmów (m.in. PCR, real-time PCR, LAMP, sekwencjonowanie, mikromacierze fenotypowe), w tym grzybów termoopornych, w celu podniesienia jakości surowców i produktów rolno-spożywczych.
Produktywność i aktywność fotosyntetyczna. Badania odpowiedzi aparatu fotosyntetycznego na warunki stresowe oraz rola aparatu fotosyntetycznego w dostosowaniu się roślin do zmieniających się warunków środowiskowych. Badania reakcji roślin na czynniki środowiskowe: obejmujące m.in. wymianę gazową liści (fotosyntezę, transpirację, przewodnictwo szparkowe), fluorescencję chlorofilu (wygaszanie fotochemiczne i niefotochemiczne), charakterystykę spektralną liści, zawartość chlorofilu.
 Właściwości fizyczne gleb o różnym sposobie użytkowania. Badania właściwości fizycznych gleb obejmujących opór penetrometryczny, wytrzymałość na zgniatanie, rozkład porów, tempo zwilżania z zastosowaniem wody i etanolu, oraz wskaźnik hydrofobowości.
Właściwości fizyczne gleb o różnym sposobie użytkowania. Badania właściwości fizycznych gleb obejmujących opór penetrometryczny, wytrzymałość na zgniatanie, rozkład porów, tempo zwilżania z zastosowaniem wody i etanolu, oraz wskaźnik hydrofobowości.
Analiza parametrów wzrostu roślin w różnych warunkach uprawy. Badania powierzchni i masa części nadziemnych, średnicy i długości korzeni w określonych przedziałach średnic za pomocą analizy obrazu, powierzchni właściwej, całkowitej pojemności kationowymiennej i gęstości ładunku powierzchniowego korzeni.